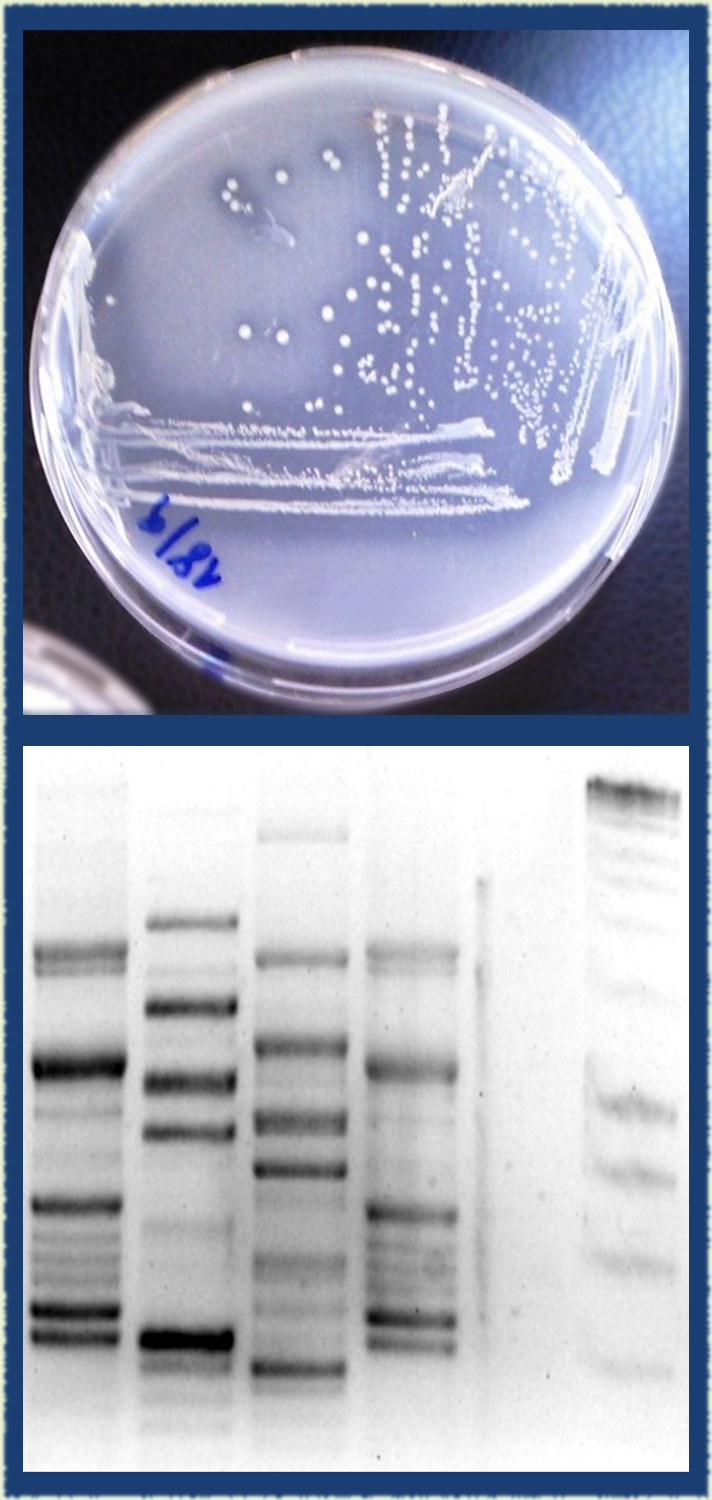

Tabla de Contenidos
Asesoramientos
En el Área Microbiología se realizan asesoramientos como parte del servicio de la UdelaR a la sociedad. En general se trata de análisis que requieren el respaldo de la Udelar o de consultorías y análisis microbiológicos poco convencionales.
Tipos de análisis realizados
Cuantificación, aislamiento, caracterización e identificación molecular de bacterias y hongos en alimentos, formulaciones farmacéuticas o de interés agrícola y ambiental. Estos análisis se realizan para determinar por ejemplo los contaminantes de un alimento, la composición de formulaciones con probióticos, la caracterización de un microorganismo patógeno vegetal o la caracterización de microorganismos que causan problemas ambientales.
Ejemplos de estos análisis aplicados a diferentes tipos de industrias:
Industria Farmacéutica
- Evaluación de actividad desinfectante frente a bacterias, hongos y/o levaduras
- Test de desafío de conservadores en formulaciones farmacéuticas
Industria Alimentaria
- Análisis de sobrevivencia de hongos y levaduras en distintas condiciones de envasado
- Cuantificación y caracterización de microorganismos anaerobios en alimentos envasados al vacío
- Cuantificación de microorganismos halófilos
- Determinación de calidad microbiológica en la vida útil de un alimento
- Aislamiento e identificación molecular de microorganismos asociados a bebidas fermentadas
Agrícola
- Aislamiento, caracterización e identificación molecular de bacterias, hongos y levaduras con capacidad de promover el crecimiento vegetal (incluidos agentes de control biológico)
- Detección y cuantificación molecular de microorganismos patógenos vegetales
- Tipificación de cepas bacterianas y fúngicas por métodos moleculares.
- Determinación in vitro de la sensibilidad de hongos patógenos a fungicidas
- Determinación de propiedades microbianas para la promoción del crecimiento vegetal como fijación de nitrógeno, producción de fitohormonas o producción de sideróforos
Ambiental
- Determinación de la capacidad de sedimentos industriales para producir biogás
- Determinación del potencial de emisión biológica de gases de efecto invernadero en sedimentos y suelos
- Monitoreo molecular de bacterias filamentosas en sistemas de tratamiento biológico de efluentes y cursos de agua
- Detección de sobrevivencia de microorganismos patógenos en lodos de sistemas de tratamiento de efluentes
- Cuantificación de bacterias relacionadas con la corrosión de metales
- Efectos de vertimientos en la biodiversidad microbiana
Contacto y procedimiento
En caso de interés en la realización de un asesoramiento, ingresar a la página de Facultad de Química, pestaña Servicios a Terceros, donde se encuentra el formulario de solicitud. Se debe completar el formulario con el mayor detalle posible y enviar a la Oficina de Asesoramientos (asesor@fq.ed.uy).
En primera instancia la Oficina de Asesoramientos consulta a los encargados del Área Microbiología para saber si ese análisis se puede realizar en las condiciones solicitadas. Si el análisis es factible se estima su costo y el tiempo necesario para su realización. La Oficina de Asesoramientos comunica al solicitante el costo del asesoramiento y, con esta información, el solicitante decide si confirmará la solicitud.
El solicitante recibirá un informe de los resultados del asesoramiento en el tiempo estipulado en la cotización.
Por consultas puntuales al Área Microbiología dirigirse al mail asesoramiento.microbiologia.fq@gmail.com indicando nombre, ocupación y dirección de quien consulta.